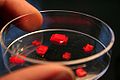

Dichromate de potassium
Le dichromate de potassium, aussi nommé bichromate de potassium, est un solide ionique orange de formule K 2 Cr 2 O 7.
Catégories :
Composé du potassium - Chromate - Pigment - Procédé photographique - Photographie argentique - Technique photographique - Technique cinématographique
Recherche sur Google Images :
Source image : artdec.ca Cette image est un résultat de recherche de Google Image. Elle est peut-être réduite par rapport à l'originale et/ou protégée par des droits d'auteur. |
Page(s) en rapport avec ce sujet :
- documentation de référence sur Dichromate de potassium... Le dichromate de potassium, aussi nommé bichromate de potassium, est un solide ionique de formule K2Cr2O7.... Le dichromate de potassium est surtout utilisé dans les ... (source : dictionnaire.sensagent)
- 17 messages - Dernier message : 6 juin 2005 Pour le permanganate sous forme solide, un site de vente indiquait une conservation de 60... Le dichromate de potassium est cancérigène.... (source : forums.futura-sciences)
- A titre d'exemple, l'oxyde chromique est un solide vert. Dans les chromates et les dichromates, le chrome a une valence de +6. Le dichromate de potassium est un... (source : edunet)
| Dichromate de potassium | ||||
|---|---|---|---|---|
![]() |
||||
| Général | ||||
| Nom IUPAC | Dichromate de potassium | |||
| N° CAS | ||||
| N° EINECS | ||||
| Apparence | solide cristallin rouge orange | |||
| Propriétés chimiques | ||||
| Formule brute | K2Cr2O7 | |||
| Masse molaire | 294, 184745 g∙mol-1 Cr 35, 35%, K 26, 58%, O 38, 07%, |
|||
| Propriétés physiques | ||||
| T° fusion | 398 °C | |||
| T° ébullition | 500 °C décomposition | |||
| Solubilité | 4, 9 g/100 ml (0 °C, eau) | |||
| Masse volumique | 2, 676 g/cm³, solide | |||
| Thermochimie | ||||
| S0solide | 291, 2 J. K-1. mol-1 | |||
| ΔfH0solide | -2033 kJ/mol | |||
| Précautions | ||||
|
|
||||
|
||||
| Phrases R | 8, 21, 25, 26, 34, 42/43, 45, 46, 48/23, 50/53, 60, 61, | |||
| Phrases S | 45, 53, 60, 61, [1] | |||
| Transport |
|
|||
|
|
||||
Le dichromate de potassium, aussi nommé bichromate de potassium, est un solide ionique orange de formule K2Cr2O7.
Dans l'eau, il se dissocie en ions dichromate et en ions potassium.
L'ion dichromate (Cr2O72-) étant un puissant agent oxydant, ce produit est fréquemment utilisé dans les réactions d'oxydo-réduction en laboratoire et dans l'industrie. Comme l'ensemble des composés du chrome hexavalent le dichromate est dangereux pour la santé.
Utilisation
Le dichromate de potassium est surtout utilisé dans les alcootests. En effet, l'éthanol est un alcool primaire qui, en présence d'un excès d'oxydant, s'oxyde en acide éthanoïque selon la réaction :
- 3CH3CH2OH + 2K2Cr2O7 + 8H2SO4 → 3CH3COOH + 2Cr2 (SO4) 3 + 2K2SO4 + 11H2O
La réaction est catalysée par du nitrate d'argent. L'ion dichromate est orangé et la couleur passe au vert (couleur des ions chrome III) avec la réaction, indiquant par là la présence ou non d'alcool.
Par réaction avec l'acétate de plomb il donne le chromate de plomb (PbCrO4), solide insoluble, beaucoup utilisé comme pigment : le jaune de chrome. Le plomb est désormais interdit dans les peintures à cause de sa toxicité, étant un facteur de saturnisme.
Allergies
Le bichromate de potassium provoque des allergies, en particulier des eczémas atopiques ou de contact, chez les personnes sensibles au chrome. Il est particulièrement complexe de ne pas être en contact avec le chrome, car des sels de chrome (dont le bichromate de potassium) sont présents en de nombreuses circonstances, surtout le tannage du cuir et le travail du ciment.
Images
- Secret de Pouilly-le-Fort : sur l'utilisation (non publiée) du bichromate de potassium par Pasteur lors des expériences de vaccination contre le charbon à Pouilly-le-Fort et sur la mesure dans laquelle cela peut être reconnu comme un plagiat à l'égard d'Henry Toussaint.
Notes et références
- ↑ dichromate de potassium sur ESIS, consulté le 11 février 2009
- ↑ Entrée du numéro CAS 7778-50-9 dans la base de données de produits chimiques GESTIS de la BGIA (organisme allemand responsable de la sécurité et de la santé au travail) (allemand, anglais), accès le 27 novembre 2008 (JavaScript indispensable)
Recherche sur Amazone (livres) : |
Voir la liste des contributeurs.
La version présentée ici à été extraite depuis cette source le 14/04/2009.
Ce texte est disponible sous les termes de la licence de documentation libre GNU (GFDL).
La liste des définitions proposées en tête de page est une sélection parmi les résultats obtenus à l'aide de la commande "define:" de Google.
Cette page fait partie du projet Wikibis.

Accueil
Recherche
Début page
Contact
Imprimer
Accessibilité